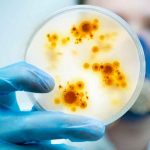
ciencia, virus, china, descubrimiento, estudio

Etiqueta: virus
Costa Rica registra 69 por ciento menos casos de dengue
Costa Rica reportó mil 766 casos de dengue desde enero hasta el 17 de julio pasado, el 69 por ciento menos que en igual...
Honduras: Salud confirma un tercer caso por hongo negro
La jefe del Laboratorio Nacional de Vigilancia de Salud, Mitzi Castro, confirmó este viernes que se ha detectado un nuevo caso de ‘Hongo Negro’,...
Descubren nuevo virus gigante en el lugar más profundo del océano
Un equipo de investigación chino que descubrió una serie de virus gigantes que habitan en el fondo de la fosa de las Marianas; el...
Detectan mosquitos transmisores del virus del Nilo Occidental en los EEUU
El Distrito de Control de Vectores del Gran Condado de Los Ángeles en EE.UU. anunció el jueves 23 de julio; la confirmación de las...
Descubren nuevos virus de 15.000 años de antigüedad en glaciares de China
Un grupo de científicos dedicado al estudio de hielo glaciar descubrieron virus de casi 15.000 años de antigüedad en dos muestras tomadas en una...
El extraordinario caso del hombre que dio positivo 43 veces por covid-19
En marzo de 2020, Dave Smith, un instructor de manejo británico de 72 años, se contagió de covid-19. Smith tenía una serie de afecciones...
China confirma la primer muerte de una persona a causa del virus del mono
Las autoridades sanitarias chinas confirmaron este viernes el primer caso de muerte de una persona a causa del virus B; también conocido como 'herpes B'...
Identifican primer caso de viruela de mono en Texas, Estados Unidos
Un hombre residente de Texas, Estados Unidos, que había volado a Atlanta desde Nigeria y que su destino final era el aeropuerto Dallas Love,...
¿Sabes cuál es? Alertan por nuevo video viral en Facebook
Usuarios de Facebook, la red social más popular de la web, alertaron sobre un riesgo que se está viralizando a través del servicio de...
Nicaragua con altos niveles de contención ante virus y bacterias
El Centro de Nacional de Diagnóstico y Referencia (CNDR), ubicado en el Complejo Conchita Palacios del Ministerio de Salud en Nicaragua (MINSA); ahora cuenta...